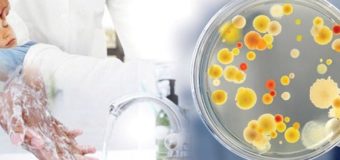

отруєння
З початком 2026 року епідеміологічна ситуація на Волині затьмарилася випадками важкого харчового отруєння. Станом на кінець лютого в…
Лютий 27, 2026На сайті Дубечненської громади оприлюднили поради щодо профілактики гострих кишкових інфекцій та харчових отруєнь. Особливу увагу жителів закликали…
Травень 06, 2025У Любомлі від отруєння невідомою речовиною помер 4-річний хлопчик. Сталося це 2-го серпня. Про це пише видання ВСН з посилання на власні джерела. У…
Серпень 06, 2023Відвідувачам луцького ЦУМу ймовірно стало поганого через збільшення концентрації дезінфікуючої речовини, якою обробляють поверхні у закладі, тому відбулась…
Березень 31, 2022Медики закликають не займатися самолікуванням і надають раціональні поради. Гриби є доволі специфічним продуктом, що містить значну кількість…
Червень 18, 2020У селі Стахорщина Новгород-Сіверського району Чернігівщини троє дітей 2005, 2007 та 2010 років народження отруїлися невідомою речовиною й…
Грудень 11, 201919-річний хлопець потрапив в реанімацію через отруєння наркотиками, які, за словами матері, купив у Луцьку. Про це повідомляю ІА Волинські…
Листопад 13, 2019Вчора, 11 листопада на Ківерцівщині місцевий фермер не застав на роботі двох своїх працівників, а оскільки додзвонитися не…
Листопад 12, 201930-го вересня, зранку медикам надійшло повідомлення на 103 від мешканців однієї з квартир багатоповерхівки, що неподалік суду у…
Вересень 30, 2019До обласної інфекційної лікарні протягом 11-12 липня потрапили 10 осіб внаслідок отруєння в одній з піцерій мережі “Фелічіта” в Луцьку. Про це йдеться у…
Липень 15, 2019Усі захворілі – члени двох сімей із села Боровно Камінь-Каширського району та села Рованці Луцького району. Протягом 17…
Вересень 19, 2018Завершилося епідеміологічне розслідування та ліквідація спалаху сальмонельозу в кафе «Фора» у Луцьку. Фахівці припускають, що причиною масового отруєння міг…
Вересень 05, 2018